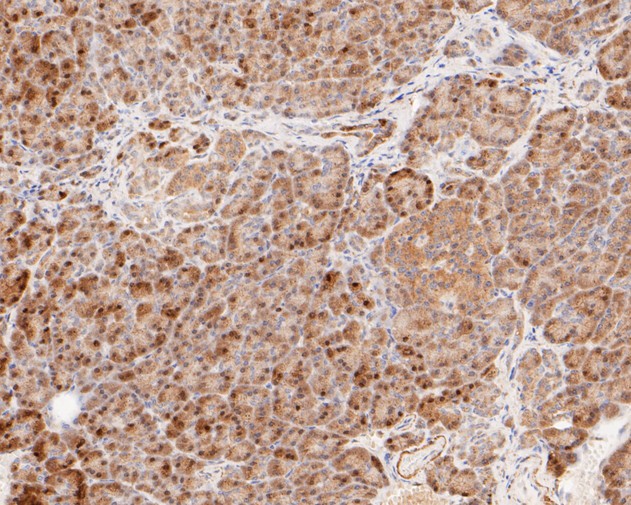

Phosphorylated. Phosphorylated in unstressed cells; this phosphorylation is constitutive and implicated in the repression of HSF1 transcriptional activity. Phosphorylated on Ser-121 by MAPKAPK2; this phosphorylation promotes interaction with HSP90 proteins and inhibits HSF1 homotrimerization, DNA-binding and transactivation activities. Phosphorylation on Ser-303 by GSK3B/GSK3-beta and on Ser-307 by MAPK3 within the regulatory domain is involved in the repression of HSF1 transcriptional activity and occurs in a RAF1-dependent manner. Phosphorylation on Ser-303 and Ser-307 increases HSF1 nuclear export in a YWHAE- and XPO1/CRM1-dependent manner. Phosphorylation on Ser-307 is a prerequisite for phosphorylation on Ser-303. According to PubMed:9535852, Ser-303 is not phosphorylated in unstressed cells. Phosphorylated on Ser-419 by PLK1; phosphorylation promotes nuclear translocation upon heat shock. Hyperphosphorylated upon heat shock and during the attenuation and recovery phase period of the heat shock response. Phosphorylated on Thr-142; this phosphorylation increases HSF1 transactivation activity upon heat shock. Phosphorylation on Ser-230 by CAMK2A; this phosphorylation enhances HSF1 transactivation activity upon heat shock. Phosphorylation on Ser-326 by MAPK12; this phosphorylation enhances HSF1 nuclear translocation, homotrimerization and transactivation activities upon heat shock. Phosphorylated on Ser-320 by PRKACA/PKA; this phosphorylation promotes nuclear localization and transcriptional activity upon heat shock. Phosphorylated on Ser-363 by MAPK8; this phosphorylation occurs upon heat shock, induces HSF1 translocation into nuclear stress bodies and negatively regulates transactivation activity. Neither basal nor stress-inducible phosphorylation on Ser-230, Ser-292, Ser-303, Ser-307, Ser-314, Ser-319, Ser-320, Thr-323, Ser-326, Ser-338, Ser-344, Ser-363, Thr-367, Ser-368 and Thr-369 within the regulatory domain is involved in the regulation of HSF1 subcellular localization or DNA-binding activity; however, it negatively regulates HSF1 transactivation activity. Phosphorylated on Ser-216 by PLK1 in the early mitotic period; this phosphorylation regulates HSF1 localization to the spindle pole, the recruitment of the SCF(BTRC) ubiquitin ligase complex inducing HSF1 degradation, and hence mitotic progression. Dephosphorylated on Ser-121, Ser-307, Ser-314, Thr-323 and Thr-367 by phosphatase PPP2CA in an IER5-dependent manner, leading to HSF1-mediated transactivation activity.; Sumoylated with SUMO1 and SUMO2 upon heat shock in a ERK2-dependent manner. Sumoylated by SUMO1 on Lys-298; sumoylation occurs upon heat shock and promotes its localization to nuclear stress bodies and DNA-binding activity. Phosphorylation on Ser-303 and Ser-307 is probably a prerequisite for sumoylation.; Acetylated on Lys-118; this acetylation is decreased in a IER5-dependent manner. Acetylated on Lys-118, Lys-208 and Lys-298; these acetylations occur in a EP300-dependent manner. Acetylated on Lys-80; this acetylation inhibits DNA-binding activity upon heat shock. Deacetylated on Lys-80 by SIRT1; this deacetylation increases DNA-binding activity.; Ubiquitinated by SCF(BTRC) and degraded following stimulus-dependent phosphorylation at Ser-216 by PLK1 in mitosis. Polyubiquitinated. Undergoes proteasomal degradation upon heat shock and during the attenuation and recovery phase period of the heat shock response.

浙公网安备 33019202000643号
浙公网安备 33019202000643号